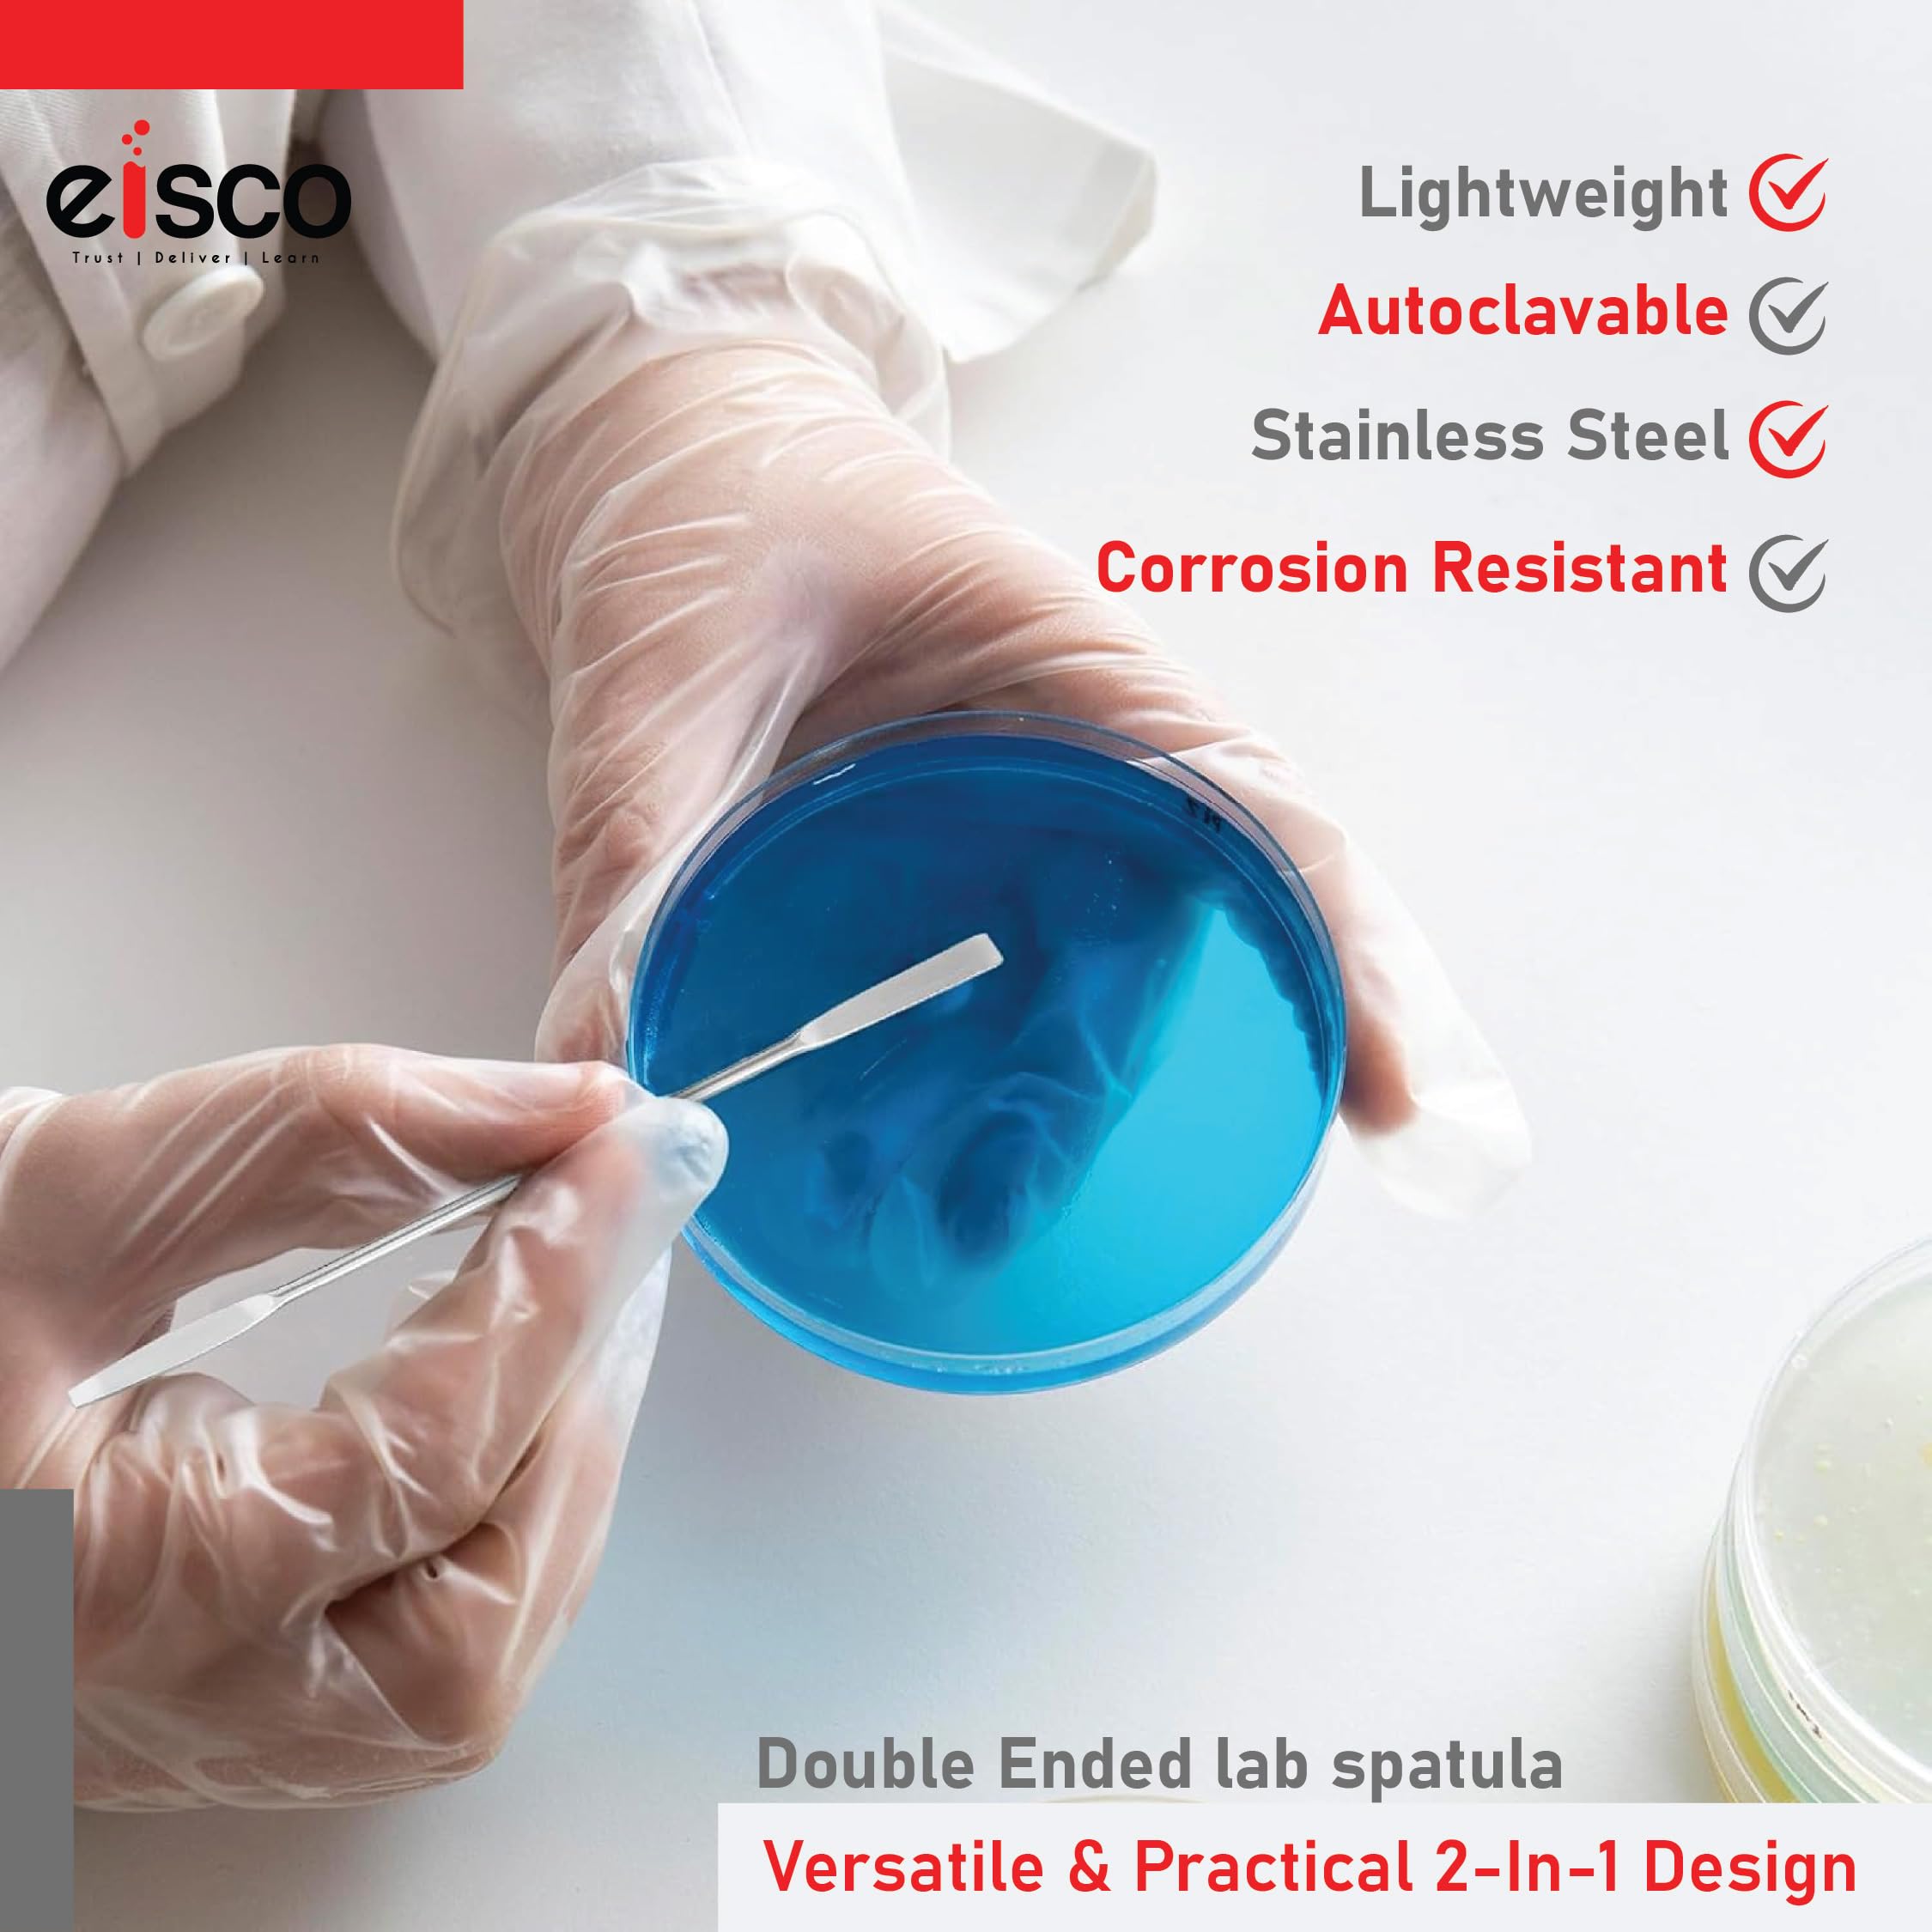
Thumbnail 8

⚡ Elevate your precision game with EISCO’s micro spatulas!
The EISCO Set of 5 Micro Spatulas offers professional-grade, double-ended stainless steel tools measuring 15cm each, designed for precise handling of powders, pastes, and materials across labs, crafts, and jewelry making. Durable, corrosion-resistant, and easy to clean, these spatulas deliver unmatched control and versatility for both professional and creative applications.
| Manufacturer | EISCO |
| Country of Origin | India |
| Item part number | CH0635D/PK5 |
| Package Dimensions | 14.4 x 8.2 x 4 cm; 20 g |
| ASIN | B076F67KTG |
Trustpilot
3 weeks ago
2 weeks ago
2 months ago
2 months ago